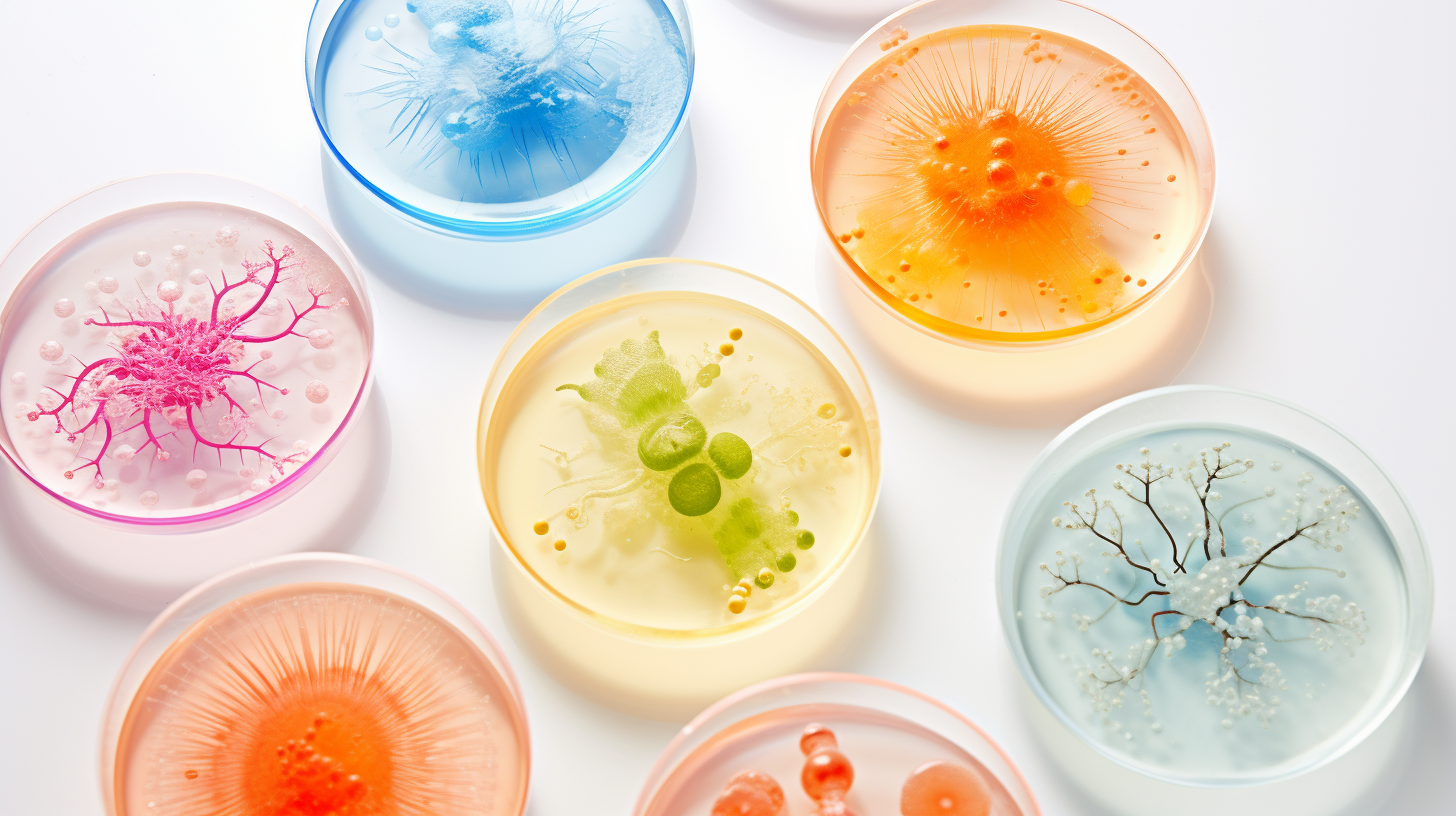

ECIS® Z-Theta von Applied BioPhysics
Impedance measurement of cell cultures
Cells are incubated continuously
Measurement and data acquisition in real time
Label-free method of cell observation










Observe your cells in a completely new way
Applied BioPhysics is known for Electric Cell-substrate Impedance Sensing (ECIS) for non-invasive and label-free monitoring of cells. They offer the system Z-Theta which measures impedance and capacity via gold electrodes in cell cultures.
In addition, a wide range of accessories such as 8-, 96-, flow or special arrays which are equipped with 1, 10 or inter-digitated finger electrodes.
A specific tool of ECIS for wound healing is integrated in the user-friendly software of the device. High currencies for a defined period of time are applied to kill the cells on the electrode. If these voltages are applied for a very short period even electroporation methods are possible.
Latest addition is the TEERZ-device which allows measurement of TEER in standard plates with filter inserts. Cartridges with electrode pins enable analysing barrier function of endothelial and epithelial cells.

1
ECIS® Z-Theta with 96-well Array Station

2
16-well Array Station

3
ECIS® Z-Theta with TEERZ-Station

4
TEERZ Cartridge

5
8-well Array with one gold electrode per well
Request information about ECIS® Z-Theta von Applied BioPhysics now

Impedanzanalysatoren: ECIS® Z-Theta von Applied BioPhysics
Impedance measurement of cell cultures
Product classification ECIS® Z-Theta von Applied BioPhysics
Product categories
Applications
Manufacturers of similar products
Advertisement
Find ECIS® Z-Theta von Applied BioPhysics and related products in the theme worlds
Topic world Cell culture technology
Cell culture technology is a central pillar in biotechnological and pharmaceutical research and development. It enables the growth and maintenance of cells under controlled laboratory conditions, providing a window into the molecular and cellular processes of life.
Topic world Cell culture technology
Cell culture technology is a central pillar in biotechnological and pharmaceutical research and development. It enables the growth and maintenance of cells under controlled laboratory conditions, providing a window into the molecular and cellular processes of life.